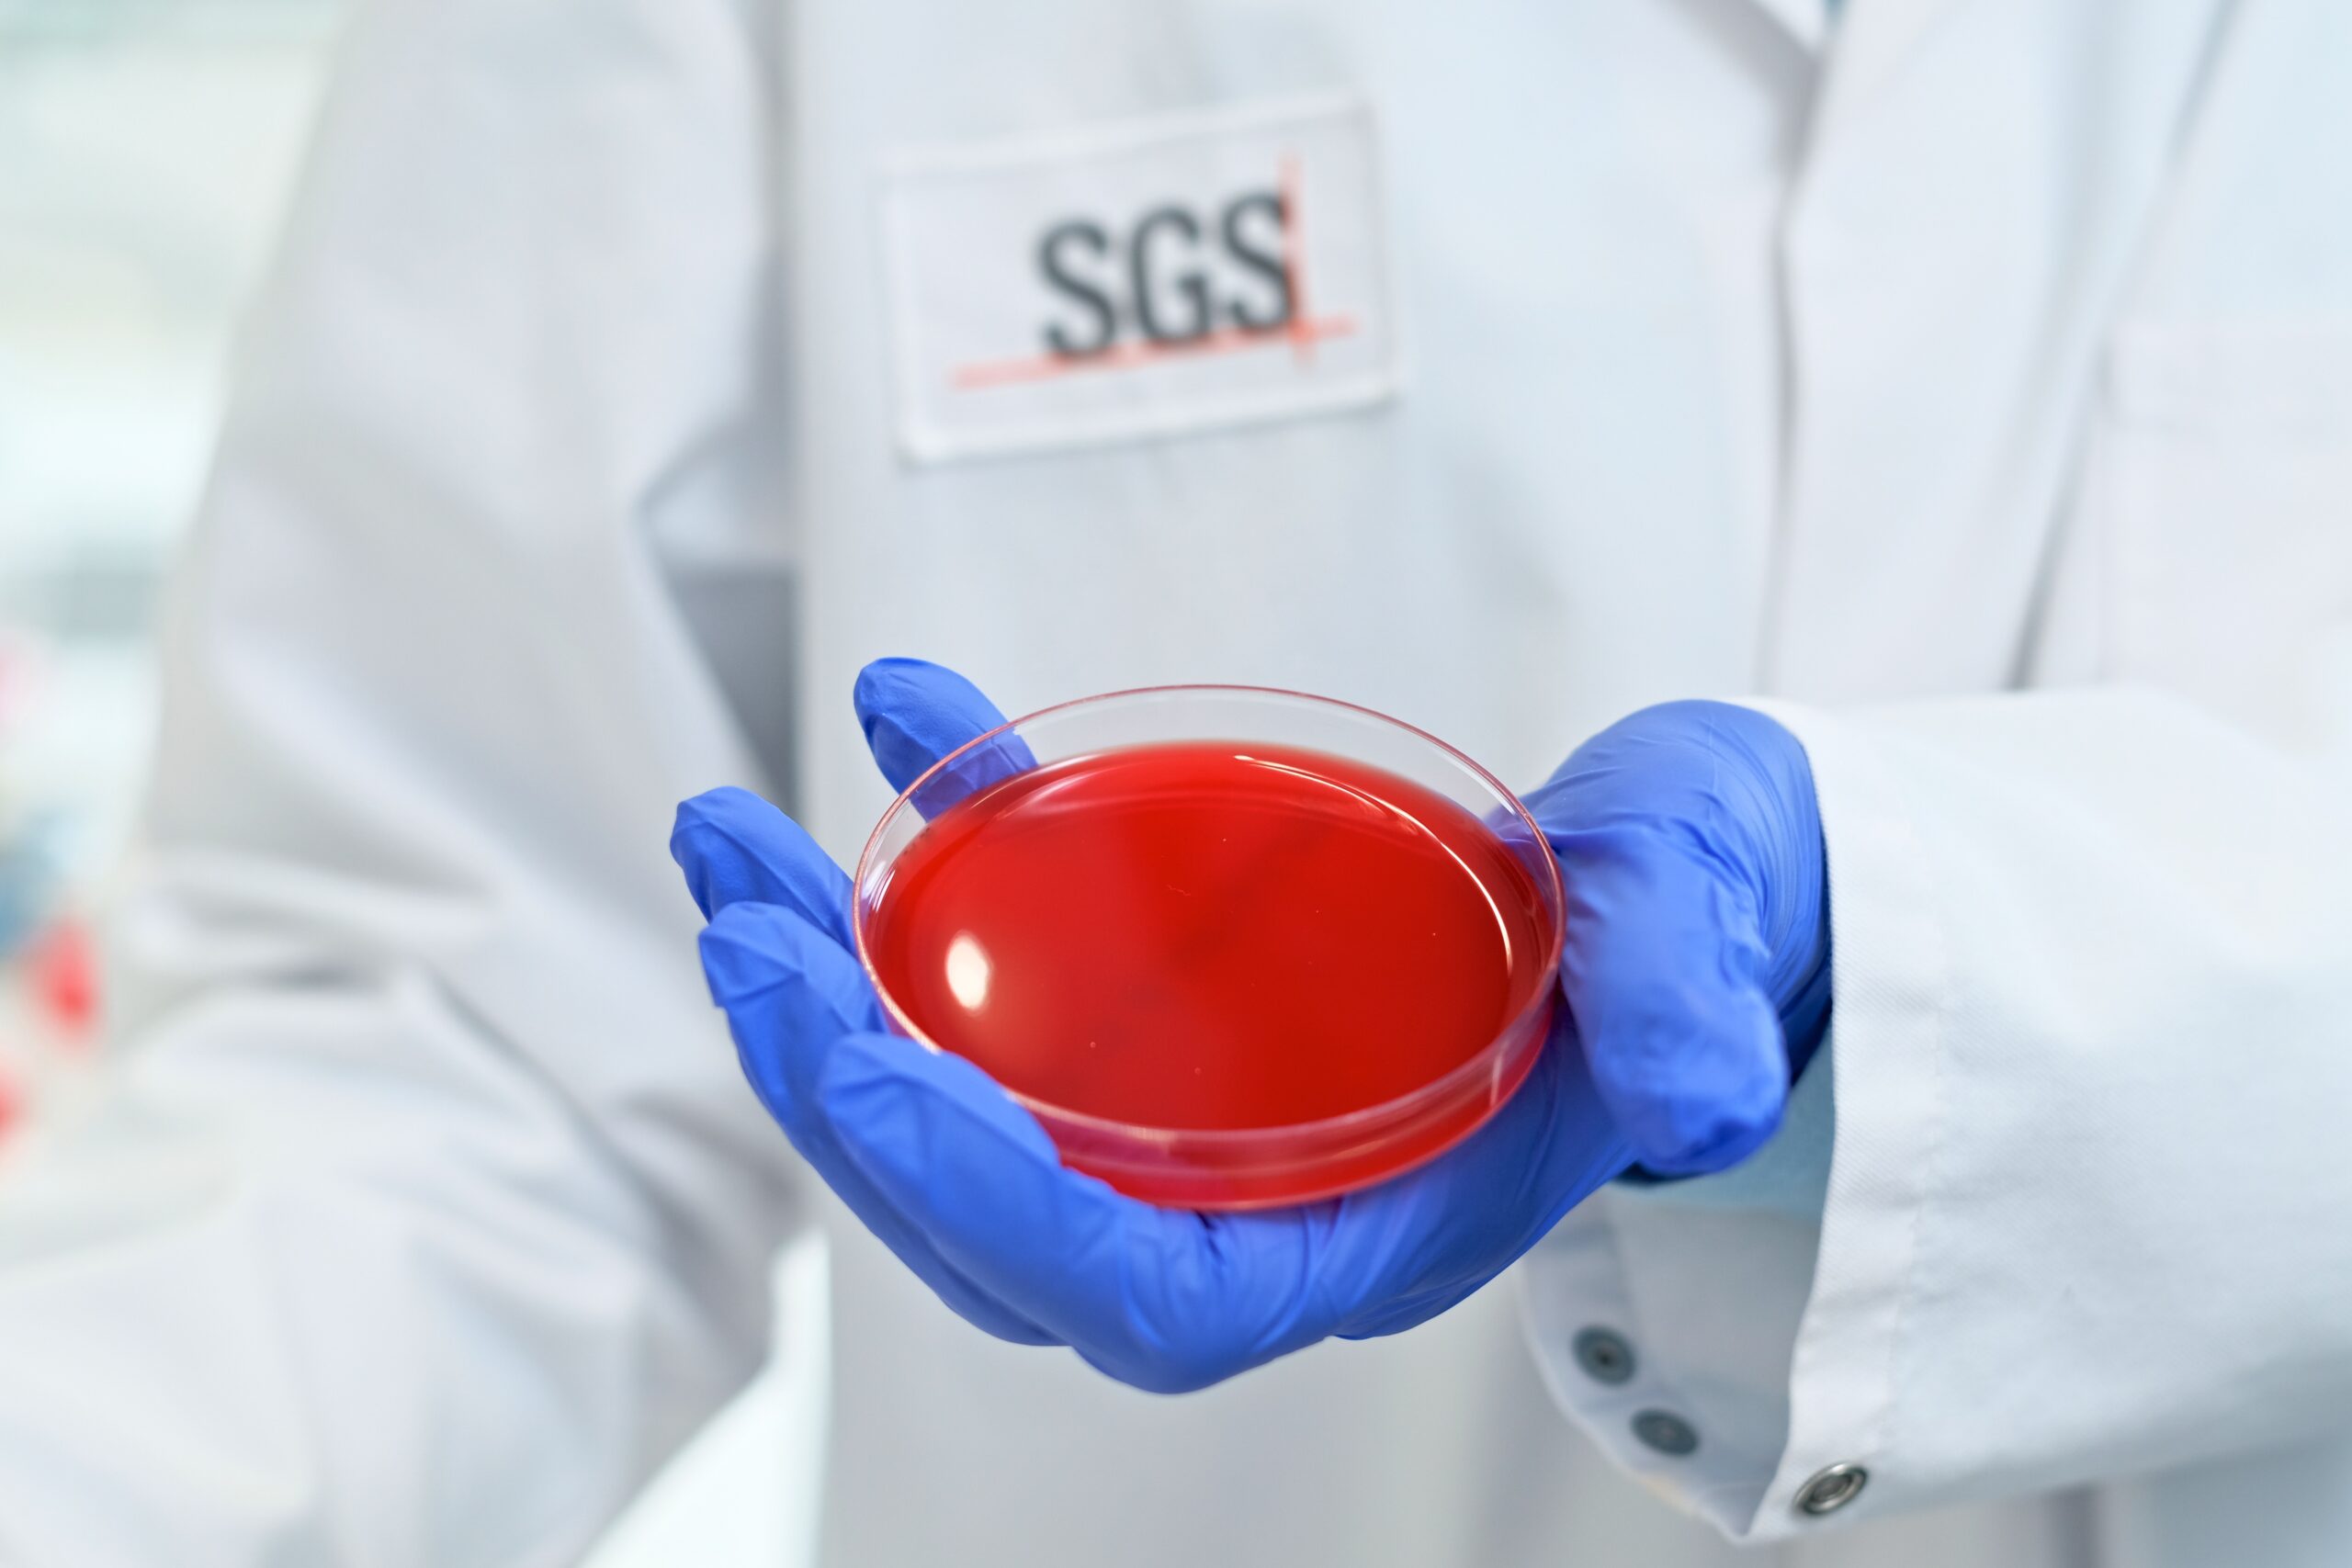

Ausbildende Firma
SGS Analytics Germany GmbH
Gewerbegebiet Hauptstraße, Markkleeberg
Anforderungen an die/den Bewerber/in
Ausbildungsinhalte
- Praxisnahe Laborausbildung mit Proben, Produkten und Prozessen.
- Analyse & Qualitätsprüfung von Stoffen, Materialien und chemischen Abläufen.
- Vielfältige Untersuchungsmethoden und Arbeit mit modernen Messgeräten.
- Auswertung & Dokumentation deiner Ergebnisse für Forschung und Qualitätssicherung.
- Abwechslungsreiche Einblicke in mehrere Laborbereiche und Spezialgebiete.
Eine Verkürzung der Ausbildung ist bei entsprechender Eignung möglich.
Qualifikationen
- (Fach-) Hochschulreife oder einen guten mittleren Abschluss
- gute Deutschkenntnisse in Wort und Schrift (C1-Niveau)
- gutes technisches Verständnis
- Sorgfalt und Verantwortungsbewusstsein
Benefits
- flexible Arbeitszeiten
- Weiterbildungsmöglichkeiten
- mobiles Arbeiten
- Gesundheitsangebote
- Zuschuss Deutschlandticket
- Jobbike
- betriebliche Altersvorsorge
- Vorteilsangebote für Einkäufe, Fitnessstudio, etc.
- Diversität und Inklusion als Teil der Unternehmenskultur
Je nach Standort, Position und Geschäftsbereich variieren diese Vorteile leicht.
Wir freuen uns auf Ihre Bewerbung!
Links zum Unternehmen
Zuletzt geändert am 23. März 2026, um 15:59 Uhr